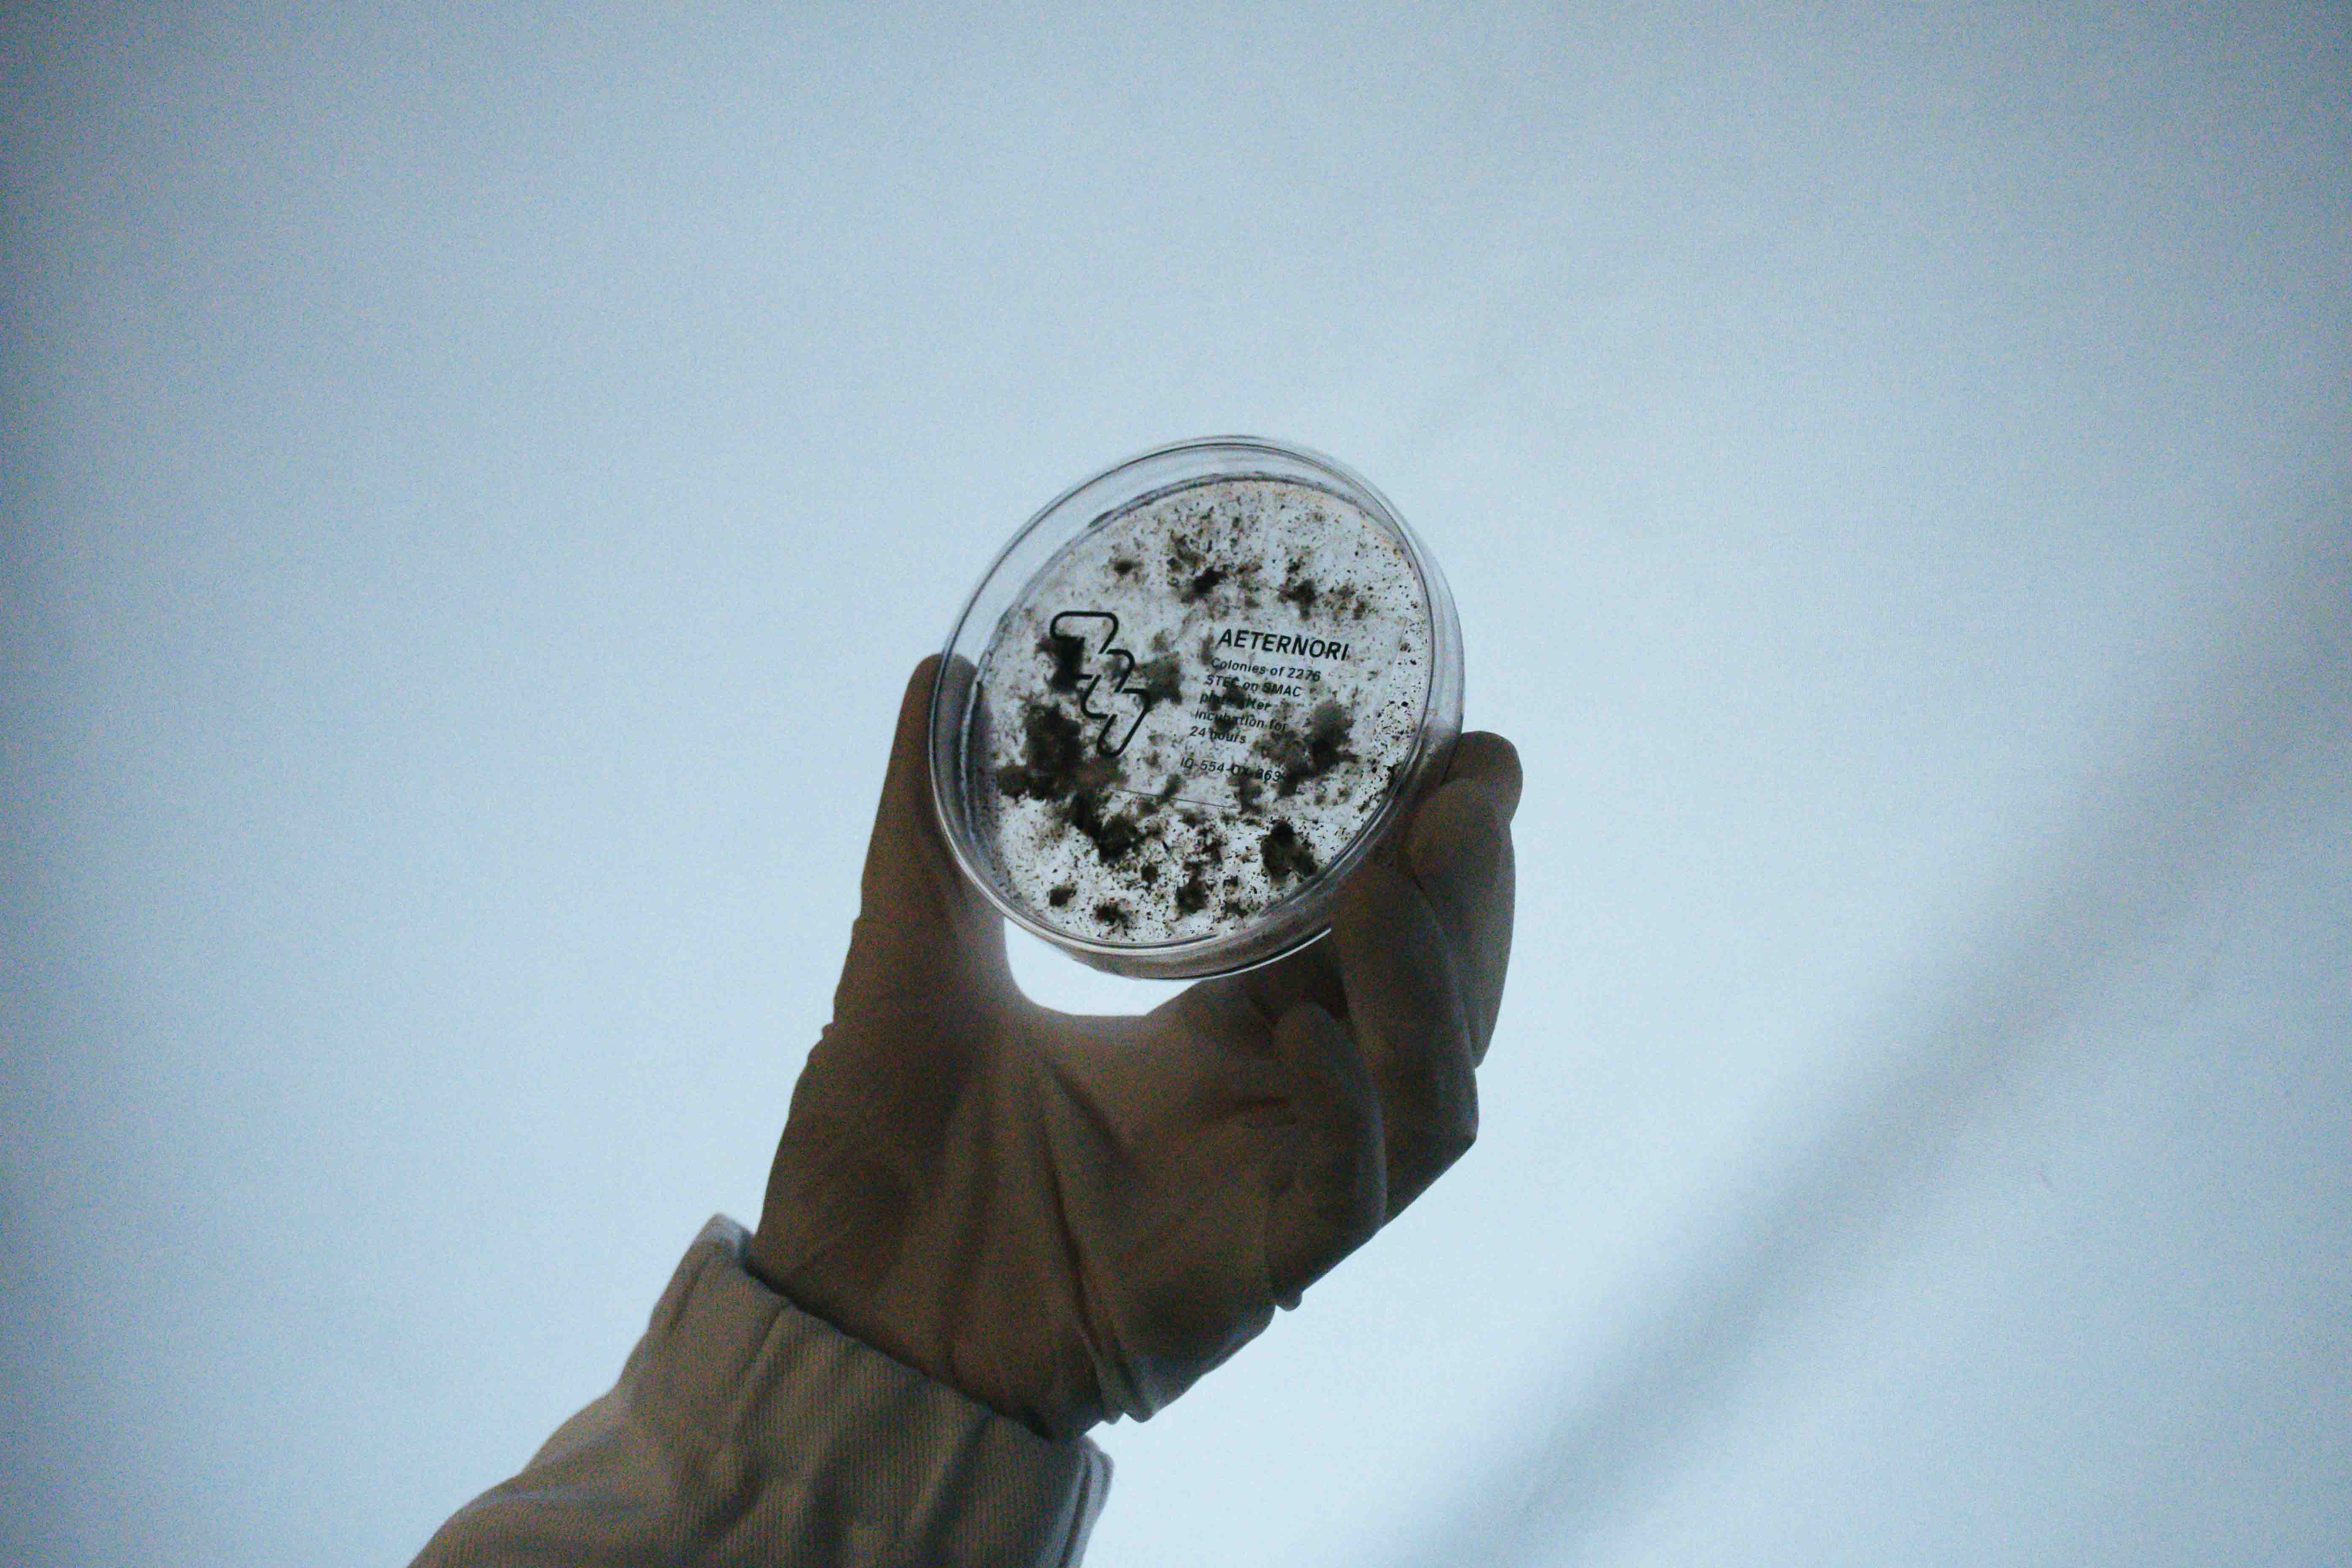
Image 1
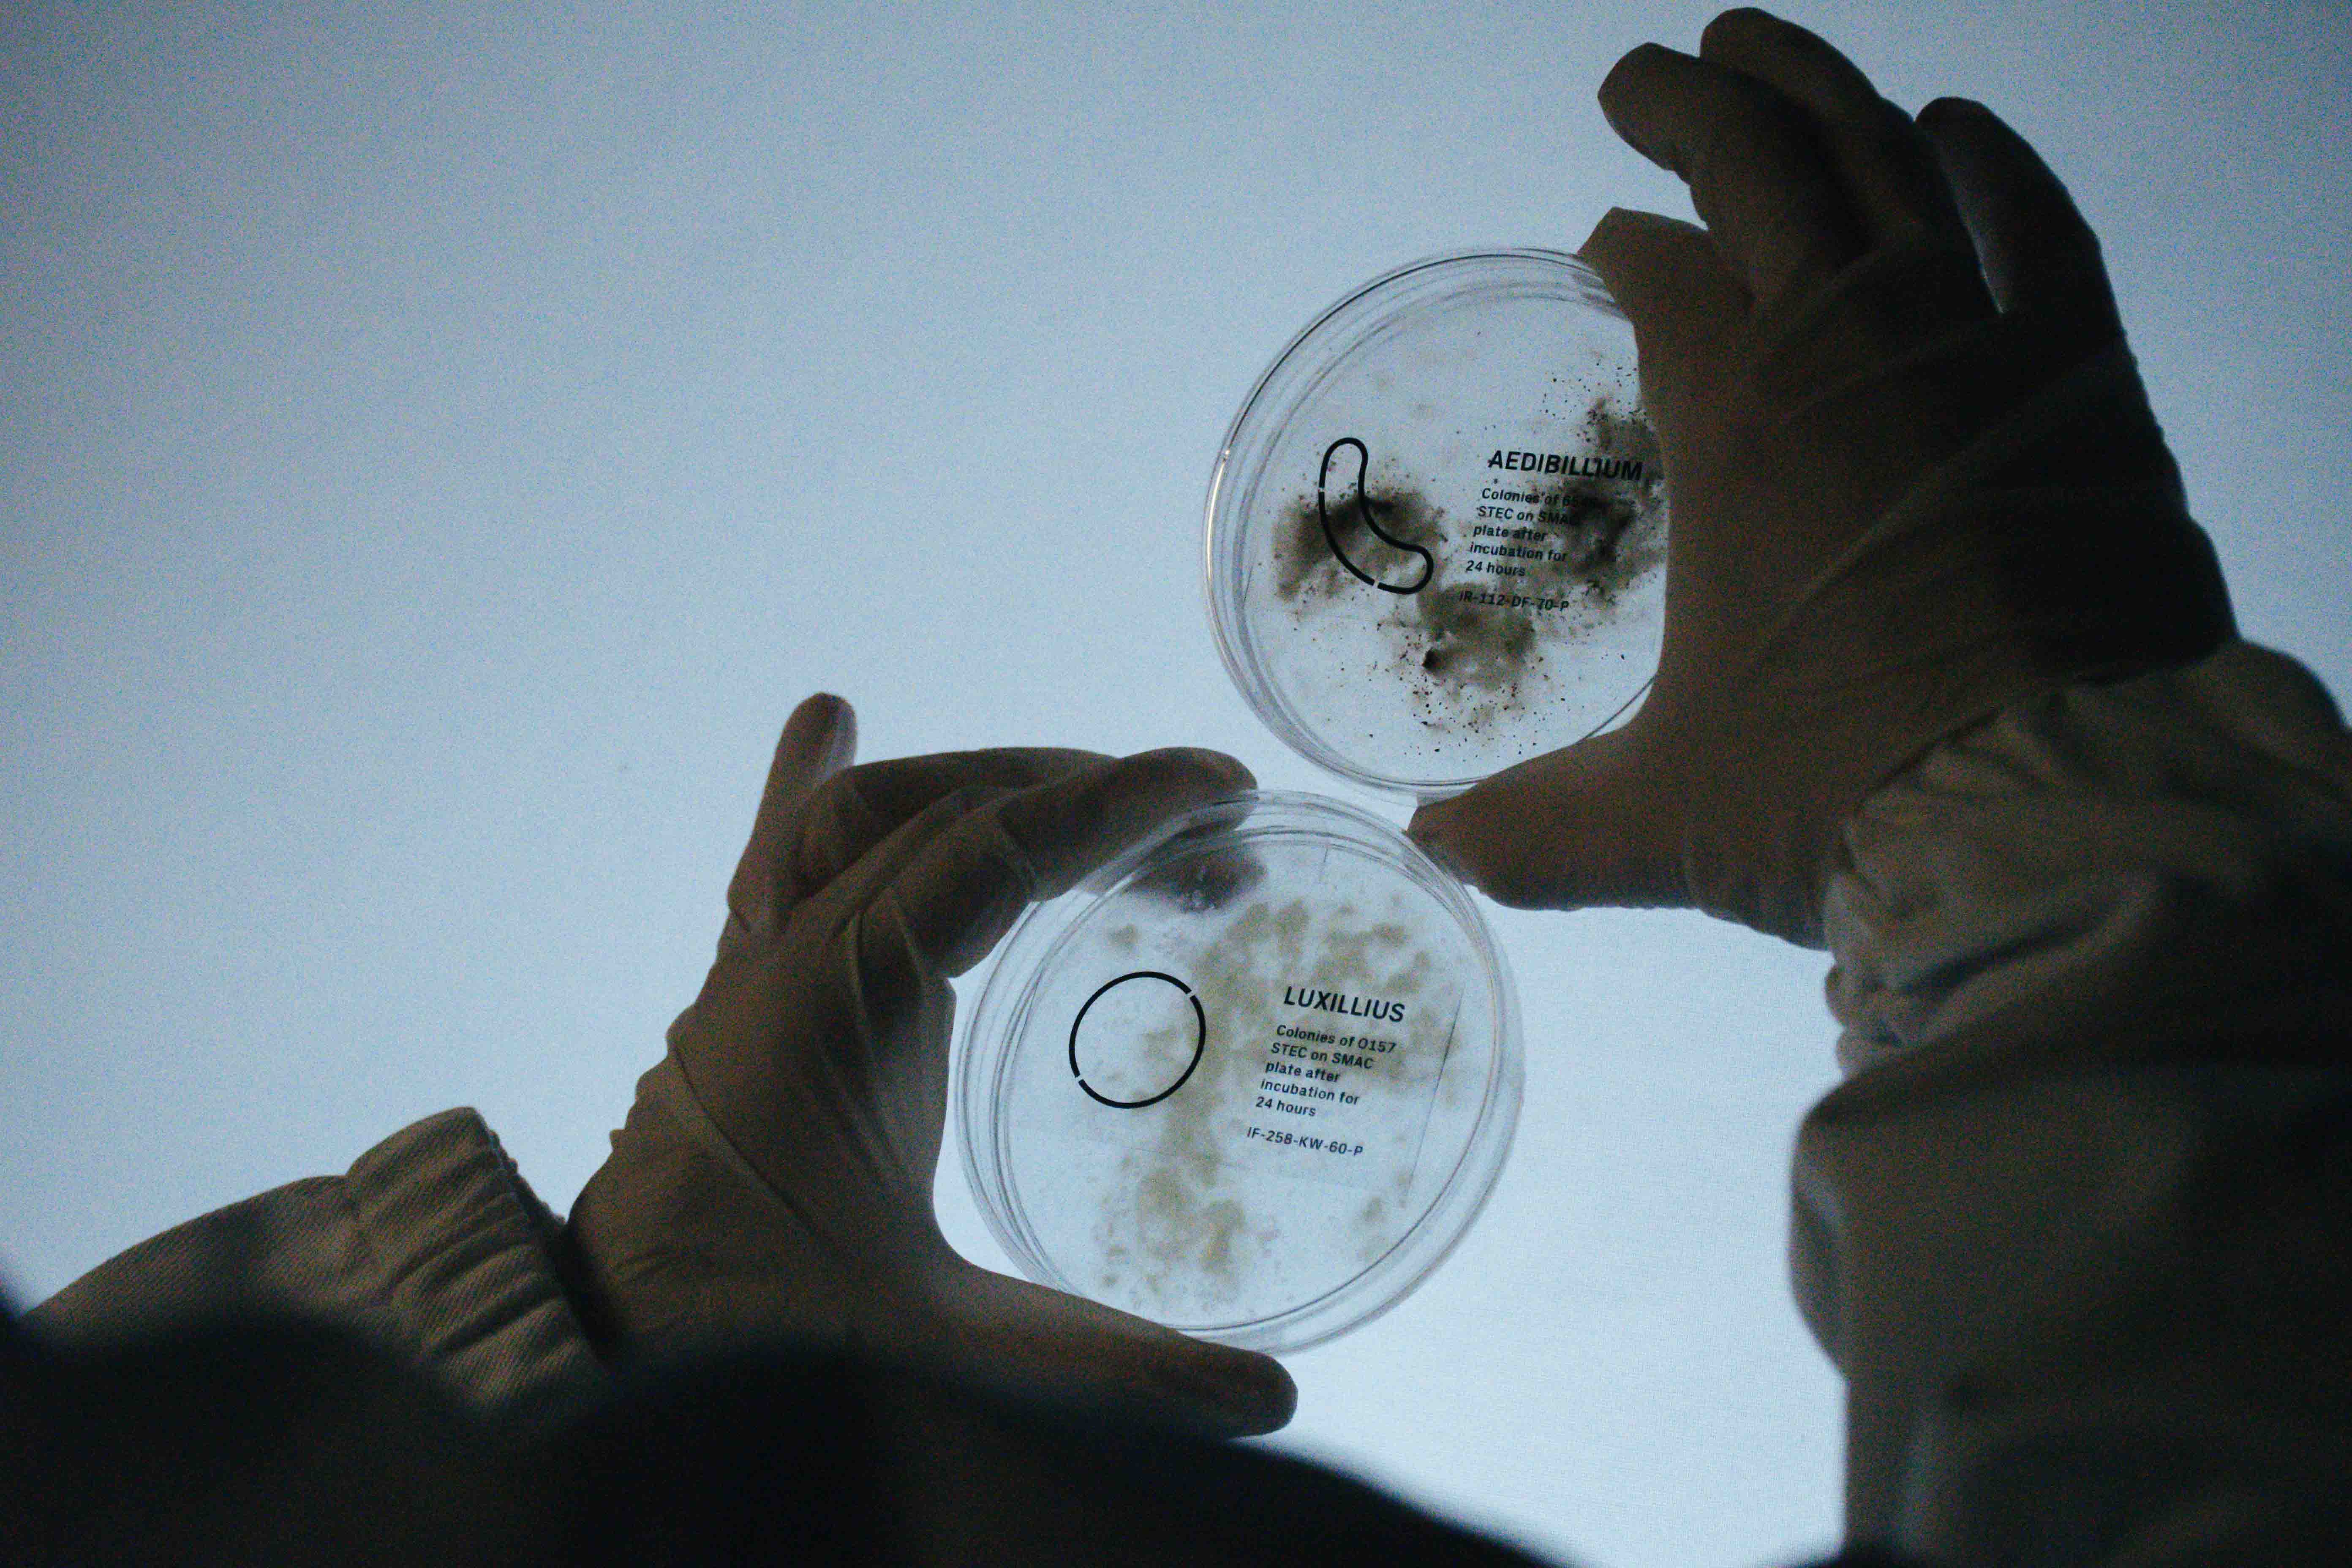
Image 3

BCTR
Face the unseen
Silenziosi e impercettibili, i batteri sono tra le forme viventi più diffuse sulla Terra. Hanno sviluppato un’incredibile capacità di adattamento che permette loro di evolversi di pari passo ai sempre più imprevedibili e catastrofici mutamenti naturali dell’ecosistema. Possono essere definiti, grazie alla loro invisibile ma forte influenza sull’intera biosfera, i “potenti” del nostro pianeta.
Quiet and almost invisible, bacteria are among the most widespread living organisms on Earth. They have developed an incredible ability to adapt to the most various conditions, being able to evolve and grow while keeping up with the ever-worsening and catastophic natural disasters. Bacteria can be defined as “the mighty ones” of our planet, thanks to their undetectable yet strong influence on the entire biosphere.